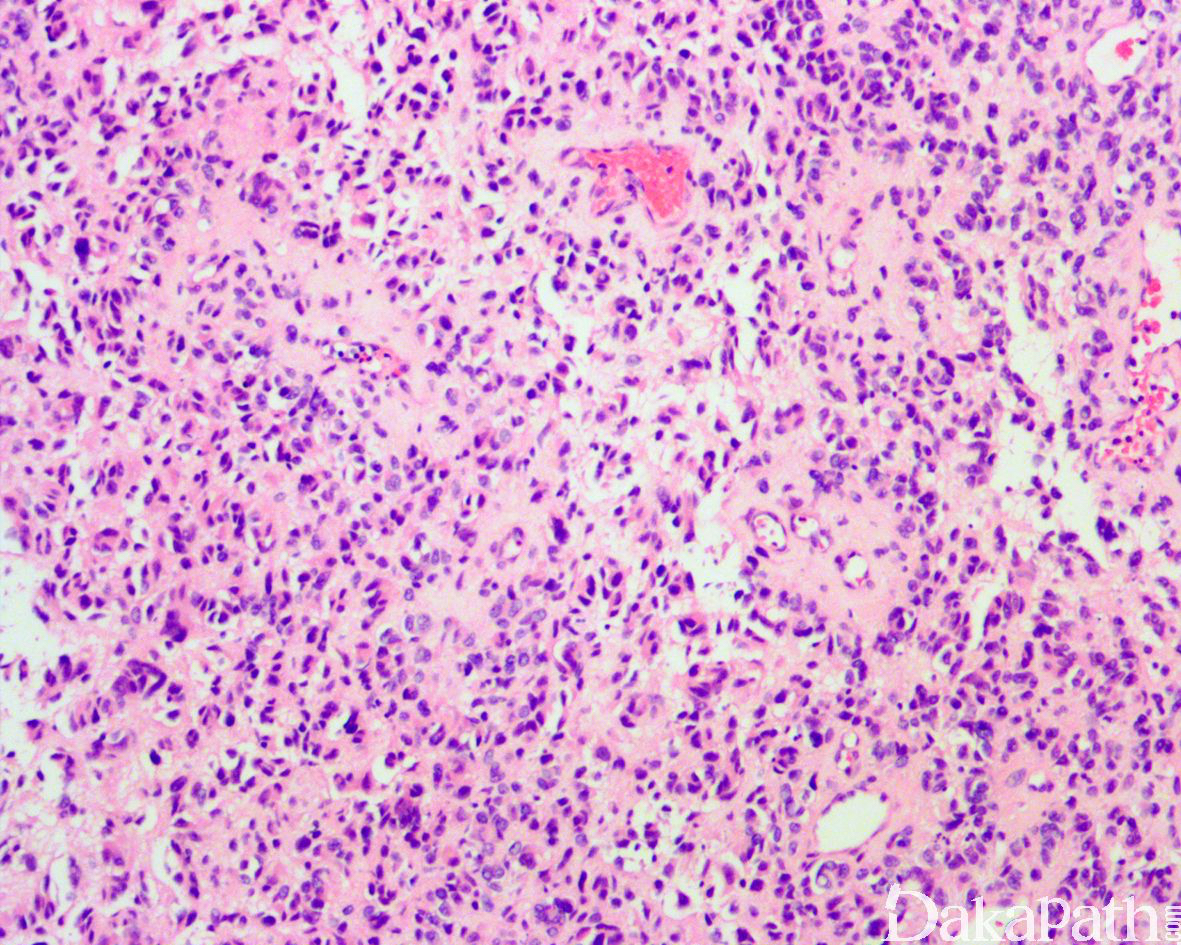

上皮样神经鞘瘤
Epithelioid Schwannoma
同义词(或曾用名): 上皮样施万细胞瘤
概述:
完全或大多数由上皮样瘤细胞构成的神经鞘瘤
发病部位: 肢端>躯干,偶见于内脏器官(绝大多数位于胃肠道)
诊断要点:
13-75 岁(中位 45 岁),多数位于真皮或皮下组织内,偶见于肌内,界限清晰或有包膜,肿瘤平均直径 1-2cm;
镜下较大的肿瘤呈多结节状或分叶状生长,小圆形上皮样施万细胞呈实行片状、单个、小巢状或呈条束状排列;
间质为胶原性或部分伴有黏液样变性;
瘤细胞胞浆较丰富、嗜酸性或浅染,核圆形或卵圆形,染色质均匀,可见小核仁,核无明显的异型性,核分裂象罕见,平均 1 个/10HPF;
少数可见退变的核非典型性表现为核大而染色质浓染不规则,其内可见假包涵体等特征,
部分区域可见类似于普通型神经鞘瘤的结构特征如局灶过渡为短梭形细胞,富于细胞过渡为少细胞区(Antoni A 区和 B 区特征),以及厚壁的玻璃样变血管等;
少数可发生恶性转化,转化为上皮样恶性外周神经鞘膜瘤,表现为弥漫的细胞异型性,核分裂象增多伴非典型核分裂等特征;
8,介于经典型上皮样神经鞘瘤和上皮样外周神经鞘膜肿瘤之间的肿瘤,如伴有一定程度的细胞异型性,核分裂象增多(> 3/10HPF)等可称之为非典型上皮样神经鞘瘤,该类肿瘤的生物学行为多为惰性。

免疫组织化学染色:
S-100. SOX10 弥漫阳性,GFAP 部分细胞阳性,无 H3K27me3 表达缺失。CK 和 EMA 一般阴性,EMA 可着染包膜处的神经束膜细胞,HMB45. Melan-A 等均阴性,约 42%可见 INI-1 表达缺失。
分子标记:
约 42%可见 SMARCB1 缺失
鉴别诊断:
软组织肌上皮瘤:弥漫表达上皮性标志物和/或 EMA,约 50%可见 EWSR1 基因重排;
骨化性纤维黏液样肿瘤:存在骨壳,免疫组化染色表达 CD10,遗传学上表现为 PHF1 基因重排:
恶性黑色素瘤:表达 HMB45 和 Melan-A 等;
低级别上皮样恶性外周神经鞘膜瘤:与上皮样神经鞘瘤可能存在形态学上的连续性,目前尚无具体的量化标准可对两者进行明确的区分。
预后:
多为惰性,偶见复发;发生高级别转化者可表现出复发和转移。
治疗:
完整切除
参考文献:
Hart J, Gardner JM, Edgar M, et al. Epithelioid schwannomas: an analysis of 58 cases including atypical variants. Am J Surg Pathol. 2016;40:704–713. Jo V Y , Fletcher C D M . SMARCB1/INI1 Loss in Epithelioid Schwannoma[J]. The American Journal of Surgical Pathology, 2017:1.
← 退变性神经鞘瘤 杂合性外周神经鞘肿瘤 →
